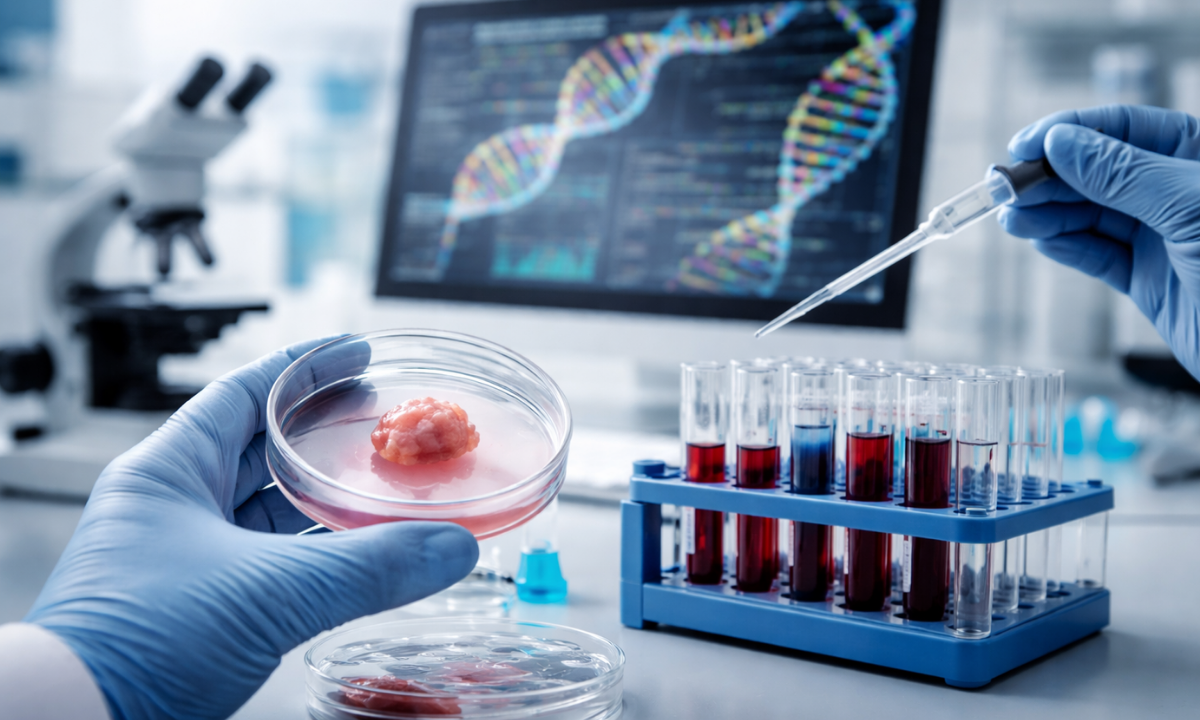
Gene Profile Test Explained

Have you ever wondered why two people with the same type of cancer can have completely different outcomes? Today, the answer often lies in understanding the DNA roadmap of the tumour and its unique genetic profile, rather than just where the cancer is located in the body.
Even at a leading cancer hospital in Bangalore, doctors are increasingly focusing on what is happening inside the tumour at a genetic level to make better treatment decisions.
In this blog, we will explore how this shift is changing cancer care and why it matters more than ever for patients and families.
Key Points at a Glance
- Cancer is no longer treated only based on location (like the lung or breast)
- A tumour’s Genetic profile reveals how it behaves and grows
- The DNA roadmap helps doctors choose targeted and personalised treatments
- A Gene profile test can guide more accurate therapy decisions
- Advanced Gene profiling methods are improving survival and reducing side effects
- Understanding your Full genetic profile can lead to better outcomes
What Do We Mean by a DNA Roadmap?

When we talk about a DNA roadmap, we are referring to a detailed map of genetic changes inside a tumour. These changes tell us how the cancer started, how it is growing, and how it may respond to treatment.
In simple terms, this roadmap helps us “read” the tumour better. Instead of guessing, we use science to understand its behaviour at a deeper level.
It also highlights specific mutations or alterations that can be directly targeted with modern cancer therapies. This means we can move away from a one-size-fits-all approach and focus on treatments that are more precise and effective. Over time, this roadmap can even help us track how the tumour is changing and adapt the treatment accordingly.
Understanding the Genetic Profile of a Tumour
Let’s first look at the genetic profile definition in simple words. It is the complete set of genetic changes or mutations found in a tumor.
These mutations are like instructions that tell cancer cells how to grow, spread, or resist treatment. When we study this profile, we get valuable clues that help us personalise care.
Example:
| Patient | Cancer Type | Genetic Profile Insight | Treatment Approach |
|---|---|---|---|
| A | Lung Cancer | EGFR mutation | Targeted therapy |
| B | Lung Cancer | No mutation | Chemotherapy |
| C | Lung Cancer | ALK rearrangement | Precision medicine |
Even though all three patients have lung cancer, their treatments are completely different. That is the power of a Gene profile.
Why Location Alone Is No Longer Enough
Traditionally, cancer treatment was based on where the tumour started. For example, breast cancer, lung cancer, or colon cancer were treated using standard protocols.
But now we know that cancers from different organs can share the same genetic mutations. This means they may respond to the same treatment, even if they are in different parts of the body.
Comparison Table:
| Old Approach | New Approach |
|---|---|
| Focus on tumour location | Focus on genetic mutations |
| Same treatment for all patients | Personalised treatment |
| Limited success in some cases | Higher success rates |
| More side effects | Targeted, fewer side effects |
This shift has completely changed how we approach cancer care.
What Is a Gene Profile Test?
A gene profile test is a diagnostic test that analyses the tumour’s DNA to identify mutations. It is usually done using a sample of tumour tissue or sometimes blood.
This test helps doctors decide which treatment will work best for a patient. It also avoids unnecessary treatments that may not be effective.
What Does It Show?
- Specific gene mutations
- Tumour behaviour patterns
- Likely response to drugs
- Risk of recurrence
Gene Profiling Methods Used Today

There are several advanced gene profiling methods that doctors use to study cancer at a molecular level. Each method provides different insights.
Common Methods:
| Method | What It Does | Benefit |
|---|---|---|
| Next-Generation Sequencing (NGS) | Reads multiple genes at once | Highly detailed analysis |
| PCR Testing | Detects specific mutations | Fast results |
| Microarray Analysis | Studies gene expression | Identifies patterns |
| Liquid Biopsy | Uses a blood sample | Less invasive |
These technologies are making cancer diagnosis more accurate and treatment more precise.
What Is a Full Genetic Profile?

A full genetic profile goes beyond a few mutations and gives a complete picture of the tumour’s DNA. It includes multiple genes, pathways, and molecular markers.
This comprehensive approach allows us to understand complex cancers better. It also opens the door to advanced therapies like immunotherapy and targeted drugs.
It can also reveal rare or hidden mutations that may not be detected in basic tests, giving doctors more treatment options. In some cases, it helps identify whether a patient is suitable for clinical trials or newer precision medicines. Most importantly, it supports long-term care planning by helping us predict how the cancer might behave in the future.
Benefits of Understanding Your Tumor’s Genetic Profile

When we study a tumour’s genetic profile, we gain several important advantages. It gives us a clearer and more accurate understanding of how the cancer behaves at a molecular level. This helps doctors choose treatments that are more targeted, rather than relying on general approaches that may not work for everyone.
It also reduces uncertainty during treatment planning, allowing both patients and doctors to make more confident and informed decisions. Over time, this approach can improve not just survival rates but also the overall quality of life during treatment.
Key Benefits:
- Personalised treatment: Therapy is tailored to the individual
- Better outcomes: Higher chances of treatment success
- Fewer side effects: Avoid unnecessary medications
- Faster decisions: Clear treatment direction
- Access to advanced therapies: Including clinical trials
Real-Life Scenario
Let’s imagine two patients with the same stage of colon cancer.
- Patient 1 has a KRAS mutation
- Patient 2 does not have this mutation
In this case, Patient 2 may benefit from targeted therapy, while Patient 1 may not. Without a gene profile test, both patients might receive the same treatment, leading to poor results for one of them.
Tips for Patients and Families
If you or your loved one is diagnosed with cancer, here are some simple steps to follow:
- Ask your doctor about a gene profile test
- Understand your tumour’s genetic profile
- Discuss personalised treatment options
- Seek care from experienced specialists
- Stay informed about new therapies
Being proactive can make a big difference in outcomes.
Final Thoughts
Cancer care is evolving rapidly, and the focus is shifting from where the tumour is located to what drives it at a genetic level. Understanding the DNA roadmap and your tumour’s genetic profile can lead to more accurate, effective, and personalised treatment options.
If you are looking for expert guidance, choosing the right cancer hospital in Bangalore can make all the difference. At Dasappa Cancer Hospital, we believe in combining advanced technology with compassionate care to give every patient the best possible outcome.
Frequently Asked Questions
1. Is gene profiling necessary for all cancer patients?
Gene profiling is not required for every cancer patient, especially in very early-stage cancers where standard treatments work well. However, it is strongly recommended for advanced, metastatic, or recurrent cancers. It helps doctors understand the tumor better and choose the most effective treatment. In many cases, it can also prevent unnecessary therapies and improve overall outcomes.
2. Is the gene profile test painful?
Gene profiling is generally not painful. In most cases, doctors use a sample from an existing biopsy, so no additional procedure is needed. Sometimes, a simple blood test called a liquid biopsy is used, which involves minimal discomfort.
Compared to other cancer-related procedures, gene profiling is considered safe, quick, and patient-friendly, making it easier to undergo.
3. How long does it take to get results?
The time required for gene profiling results usually ranges from 1 to 3 weeks, depending on the type of test and technology used. Advanced methods like next-generation sequencing may take slightly longer due to detailed analysis.
While waiting can feel stressful, these results are very important as they help doctors make accurate and personalised treatment decisions for better outcomes.
4. Is gene profiling expensive?
The cost of gene profiling can vary depending on the type of test and the number of genes analyzed. While it may seem expensive initially, it often proves cost-effective in the long run. Identifying the most suitable treatment early helps avoid unnecessary therapies and hospital visits. Many hospitals also offer packages or guidance to make these tests more accessible for patients.





